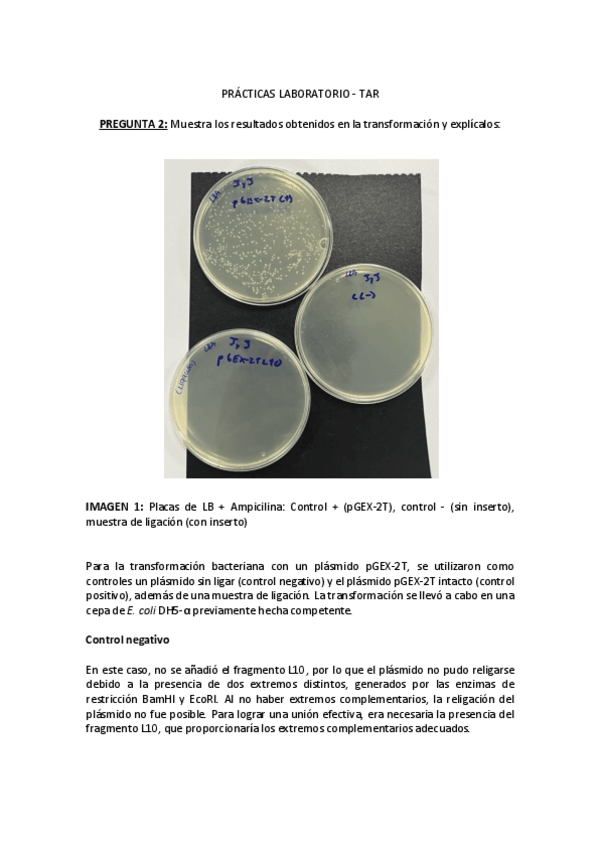
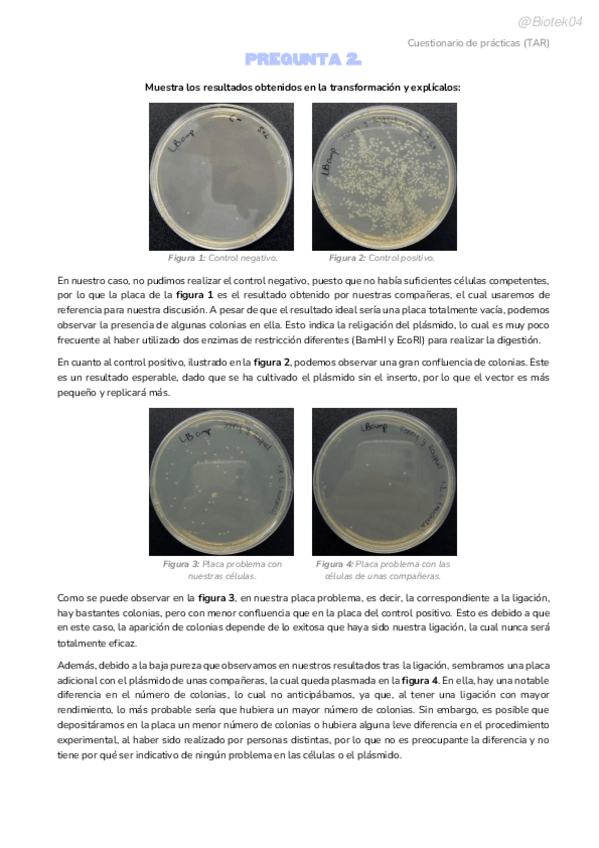

Tecnología del Dna Recombinante
He publicado nuevos apuntes de 2º Tecnología del Dna Recombinante: EJERCICIOS-T7-TFINAL.pdf
He publicado nuevos apuntes de 2º Tecnología del Dna Recombinante: APUNTES-TECNOLOGIA-DEL-DNA-RECOMB..pdf
He publicado nuevos apuntes de 2º Tecnología del Dna Recombinante: EJERCICIOS-T1-T6.pdf
apuntes
-
Apuntes tar
He publicado nuevos apuntes de 3º Tecnología del Dna Recombinante: Apuntes tar
apuntes
-
TAR resumen (9-10) Merymi
Hecho por Merymi
apuntes
-
TAR Paz
Hecho por Paz 2026
apuntes
-
Tecnología del DNA Recombinante 2026
He publicado nuevos apuntes de 2º Tecnología del Dna Recombinante: Tecnología del DNA Recombinante 2026
He publicado nuevos apuntes de 3º Tecnología del Dna Recombinante: Elementos-plasmidicos.pdf
He publicado nuevos apuntes de 3º Tecnología del Dna Recombinante: Ejericios-de-enzimas-de-restriccion-Tema-3.pdf
He publicado nuevos apuntes de 3º Tecnología del Dna Recombinante: Ejercicios-diseno-de-primers-Tema-4.pdf
He publicado nuevos examenes de 2º Tecnología del Dna Recombinante: TEORIATDRcorregit.pdf
He publicado nuevos examenes de 2º Tecnología del Dna Recombinante: TEORIATDR-repeteix-moltes-preguntes.pdf
He publicado nuevos apuntes de 2º Tecnología del Dna Recombinante: Resum-T3-La-Reaccio-en-Cadena-de-la-Polimerasa-PCR.pdf
He publicado nuevos apuntes de 2º Tecnología del Dna Recombinante: Resum-T2-Tecniques-Basiques-per-a-la-Clonacio.pdf
He publicado nuevos apuntes de 3º Tecnología del Dna Recombinante: Tema-2-Tecniques-de-Blot.pdf
He publicado nuevos apuntes de 3º Tecnología del Dna Recombinante: Tema-7-clonatge-en-llevadura.pdf
He publicado nuevos apuntes de 3º Tecnología del Dna Recombinante: Tema-6expressio-i-purificacio-de-prots-recomb.pdf
He publicado nuevos apuntes de 3º Tecnología del Dna Recombinante: Tema-5-genoteca-genomica.pdf
He publicado nuevos apuntes de 3º Tecnología del Dna Recombinante: Tema-4vectors-de-clonatge-en-E.-Coli.pdf
He publicado nuevos apuntes de 3º Tecnología del Dna Recombinante: Tema-3-PCR.pdf
He publicado nuevos apuntes de 3º Tecnología del Dna Recombinante: Tema-1-introduccio-a-la-tecnologia-del-DNA-recombinant.pdf
He publicado nuevos apuntes de 2º Tecnología del Dna Recombinante: TEMA-7-i-8.pdf
He publicado nuevos apuntes de 3º Tecnología del Dna Recombinante: TDR-conceptes-clau.pdf
He publicado nuevos practicas de 3º Tecnología del Dna Recombinante: practicas-TAR-explicadas-para-examen.pdf
apuntes
-
DNA gai guztien apunteak
He publicado nuevos apuntes de 2º Tecnología del Dna Recombinante: DNA gai guztien apunteak
apuntes
-
APUNTES TAR (2024-2025)
He publicado nuevos apuntes de 3º Tecnología del Dna Recombinante: APUNTES TAR (2024-2025)
He publicado nuevos ejercicios de 3º Tecnología del Dna Recombinante: Ejercicios-AmplificacionPCR-corregidos-por-SnapGene.pdf
He publicado nuevos ejercicios de 3º Tecnología del Dna Recombinante: Introduccion-a-SnapGene-ejercicios-de-practicas-prelab.pdf
practicas
-
TAREAS PRÁCTICAS TAR
He publicado nuevos practicas de 3º Tecnología del Dna Recombinante: TAREAS PRÁCTICAS TAR
He publicado nuevos practicas de 3º Tecnología del Dna Recombinante: Cuestionario-de-practicas.pdf
He publicado nuevos trabajos de 3º Tecnología del Dna Recombinante: Actividades-SnapGene-corregidas.pdf
He publicado nuevos examenes de 3º Tecnología del Dna Recombinante: Ejemplos preguntas TAR 2024-2025.pdf
He publicado nuevos apuntes de 2º Tecnología del Dna Recombinante: Actividad-2-Tecnologia-del-ADN-recombinante.pdf
He publicado nuevos apuntes de 2º Tecnología del Dna Recombinante: ORDENAGAILUKO-PRAKTIKAK.pdf
He publicado nuevos apuntes de 2º Tecnología del Dna Recombinante: tema-6-TDR.pdf
He publicado nuevos apuntes de 2º Tecnología del Dna Recombinante: T1operacions-basiques-del-dna-recombinant.pdf
He publicado nuevos apuntes de 2º Tecnología del Dna Recombinante: T5mutagenesis-in-vitro.pdf
He publicado nuevos apuntes de 2º Tecnología del Dna Recombinante: T4bancs-de-cDNA.pdf
He publicado nuevos apuntes de 2º Tecnología del Dna Recombinante: T3bancs-de-DNA-genomic.pdf
He publicado nuevos apuntes de 2º Tecnología del Dna Recombinante: tecnologia-del-ADN-recombinante-todo.pdf
apuntes
-
Apuntes TAR
He publicado nuevos apuntes de 3º Tecnología del Dna Recombinante: Apuntes TAR
He publicado nuevos ejercicios de 2º Tecnología del Dna Recombinante: Problemes-amb-les-solucions.pdf
He publicado nuevos apuntes de 2º Tecnología del Dna Recombinante: Apunts-T1-T5.pdf
He publicado nuevos ejercicios de 3º Tecnología del Dna Recombinante: Actividades-Enzimas.pdf